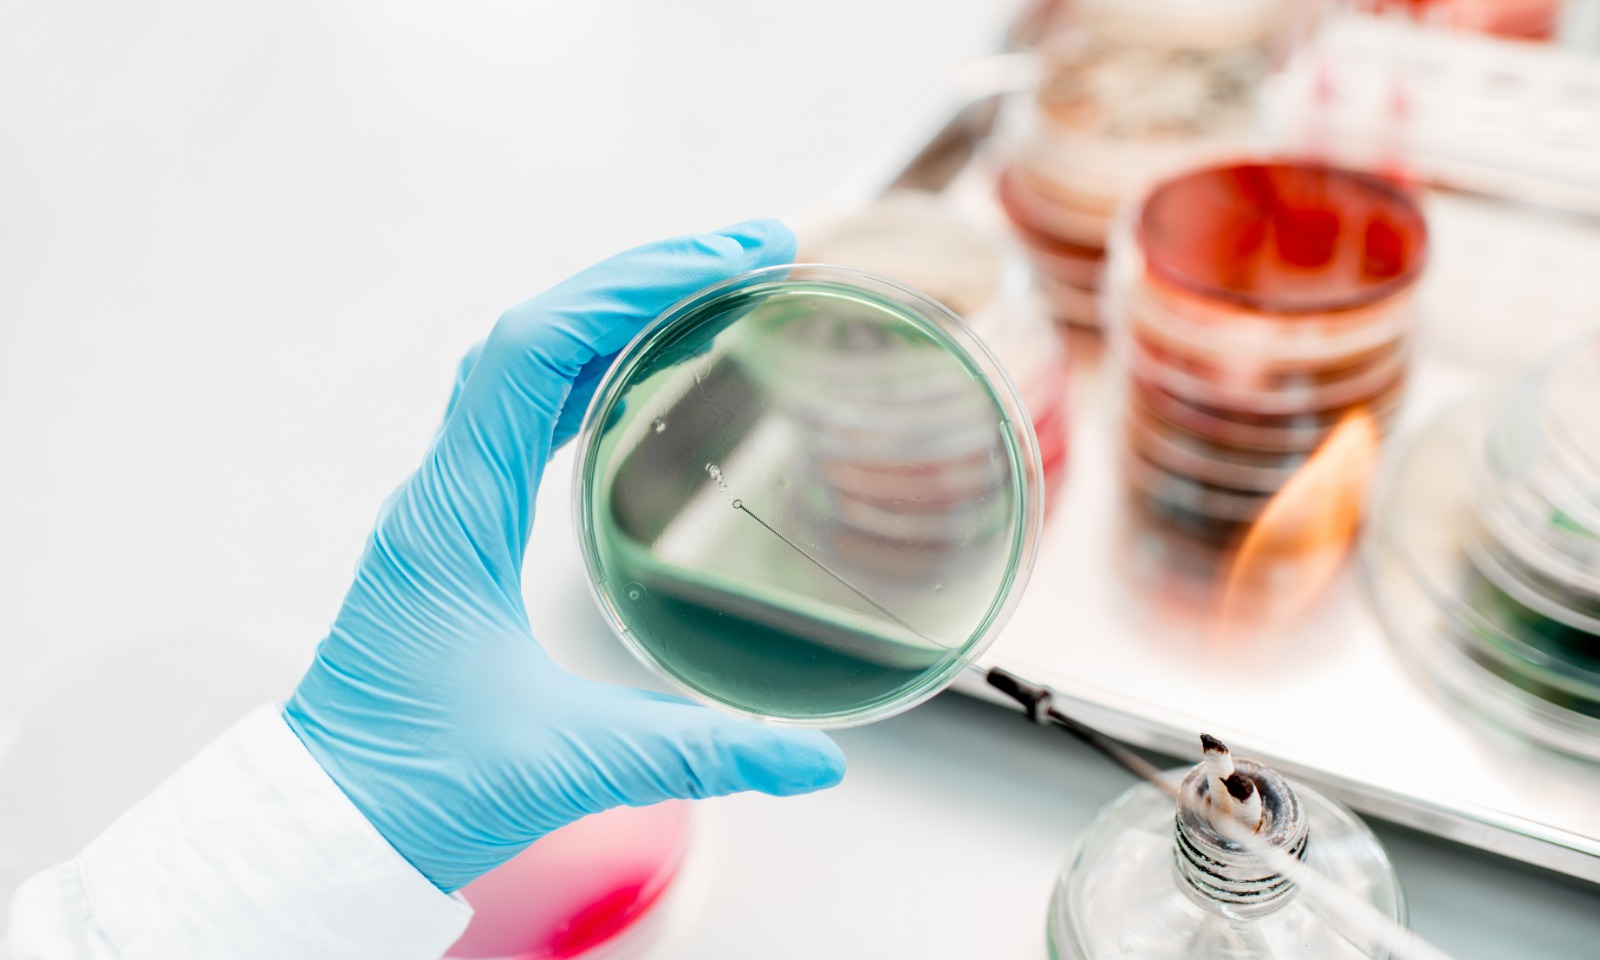

Advancing Animal Health Through Science & Collaboration
Poulpharm is a leading provider of diagnostic services, contract research, autogenous vaccines and field trials for the poultry industry.
Founded in 2006 and headquartered in Izegem, Belgium, the company has developed into a reliable and independent partner for veterinarians, veterinary pharmaceutical companies and the food industry worldwide.
Our multidisciplinary scientific team combines deep veterinary expertise with state-of-the-art laboratory technology to deliver reliable insights that support better animal health and production outcomes. Poulpharm specializes in high-quality research activities ranging from routine diagnostics to advanced (pre-)clinical studies performed in our own testing facilities.
Poulpharm operates as part of SAS-Global, an international network of excellence in animal diagnostics and research. Through our headquarters in Belgium and affiliated laboratories worldwide, we provide high-quality research services, including diagnostic investigations, field trials, (pre-)clinical studies under GCP and safety studies in our GLP-accredited facilities.
Our Facilities & Quality
Our laboratories are equipped for bacteriology, virology, molecular diagnostics, serology, histology and controlled-environment animal studies. All activities are conducted under strict quality and biosecurity procedures, including ISO 17025 accreditation and compliance with GLP and GCP standards. Quality control is integrated into every step of the process—from sample intake and data management to reporting and client follow-up—ensuring reliable and scientifically robust results.
Quality control is built into every step—from sample intake and data management to reporting and client follow-up.